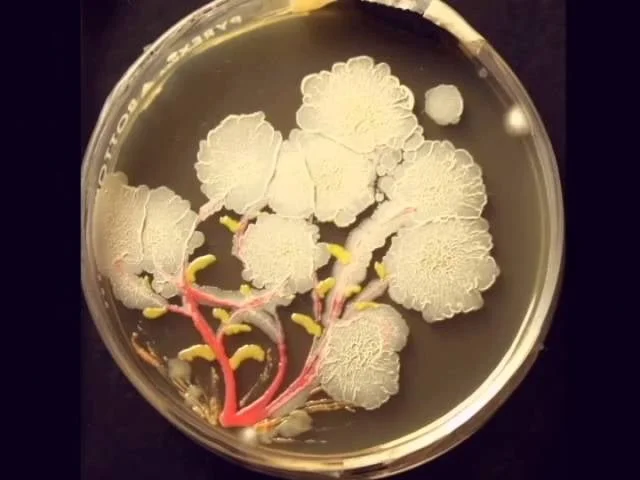

Bacterial Blossoms
McMaster University
CARING CAPACITY
More about
Caring-Capacity
This is my educational journey where I explore learning at the crossroads of science and art. Join me in asking questions, making connections, and reimagining health and sustainability.
I’ve always been fascinated by the unexpected intersections — where science starts to feel like art, where beauty products become chemistry experiments, and where personal care connects back to public health and the planet.
My process is simple but alive with wonder: I follow sparks of curiosity, I weave stories from what I learn and I see how small details connect to the bigger picture of human health and sustainability. To me, science isn’t just formulas and data. It is an art form, a way of creating meaning, and it’s endlessly fascinating.
My inspirations come from many places: the resilience of my community after wildfires, my travels, the movement for clean beauty and safe products, the elegance of scientific diagrams, and the joy of discovery. Caring Capacity is where I bring it all together…a space to share, reflect, and imagine a healthier, more compassionate future.